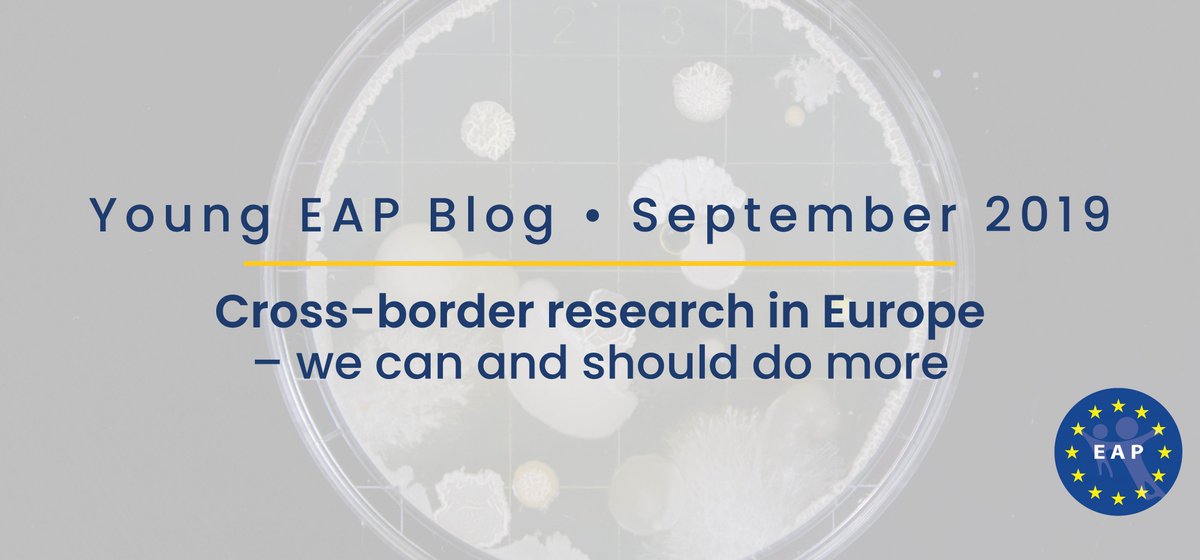
European Academy of Paediatrics (EAP) tweet media

УАПс / UAPs
23 posts

@UAPs9
Ukrainian Academy of Pediatric specialties - National umbrella for professionals pediatric societies \ Національна спілка педіатричних спеціальностей

@Vi_VIorg teaming up with @EAPaediatrics and #YoungEAP at the #VaccinationSummit19 @EU_Commission because -guess what - #VaccinesWork ! @vvkindergenees1 @stedelto @EU_Health @V_Andriukaitis

You are invited to ESPID 2020 in Rotterdam! Join colleagues and friends to learn the latest developments, exchange ideas and share experience in the field of paediatric infectious diseases.

Are you a paediatrician meeting #children on the move on a daily basis? Our "Medical care for migrant children in #Europe" Guidelines can help you! Here is our 1⃣1⃣th recommendation 👇 Full EAP article 👉 bit.ly/2xyoO9w Full infographic 👉 bit.ly/2Jtawh5



Guests this week here at @ECDC_EU! :) The 7th edition of one-week long, #ECDC observership, a programme for @ESCMID, #EUCIC and @ESCV members started yesterday :) We'll cover some of the group's activities here on Twitter :)




